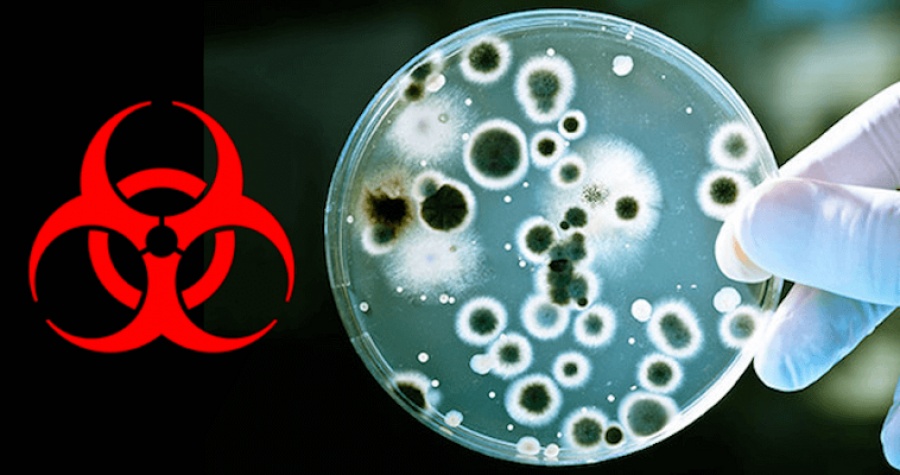
ΗΠΑ: Μια νέα στρατηγική για την αντιμετώπιση βιολογικών επιθέσεων παρουσίασε η κυβέρνηση

ΗΠΑ: Μια νέα στρατηγική για την αντιμετώπιση βιολογικών επιθέσεων παρουσίασε η κυβέρνηση
Η αμερικανική κυβέρνηση παρουσίασε σήμερα μια νέα στρατηγική για τη βέλτιστη αντιμετώπιση των βιολογικών επιθέσεων ή των ατυχημάτων.
Η νέα αυτή στρατηγική παρουσιάστηκε με την ευκαιρία της συμπλήρωσης 17 ετών από τις επιθέσεις με άνθρακα που στοίχισαν τη ζωή σε πέντε ανθρώπους στις ΗΠΑ το 2001, τις εβδομάδες που ακολούθησαν τις επιθέσεις της 11ης Σεπτεμβρίου.
Προβλέπει τη συγκρότηση μιας διυπουργικής επιτροπής βιοάμυνας υπό τον υπουργό Υγείας A. Azar, με στόχο να συντονιστούν καλύτερα οι διάφορες υπηρεσίες που μπορεί να εμπλακούν (υπουργεία Άμυνας, Εξωτερικών, Εσωτερικής Ασφάλειας, Γεωργίας κ.α.).
"Για πρώτη φορά, μια κυβέρνηση στις ΗΠΑ εφαρμόζει μια εθνική στρατηγική βιοάμυνας που καλύπτει όλο το φάσμα των βιολογικών απειλών, είτε είναι φυσικές, είτε είναι σκόπιμες, είτε πρόκειται για ατυχήματα" ανέφερε σε ανακοίνωσή του ο Αμερικανός πρόεδρος D. Trump.
Διευκρίνισε επίσης ότι κάθε χρόνο η επιτροπή θα θέτει τις προτεραιότητές της "για να προλαμβάνει, να προετοιμάζεται καλύτερα, να ανταποκρίνεται και να διαχειρίζεται τις συνέπειες" στην περίπτωση τέτοιων συμβάντων.
"Είναι πραγματικά η πρώτη συνολική στρατηγική για να δούμε τι μπορούμε να κάνουμε, πού υπάρχουν κενά, ποιες είναι ανάγκες μας και η ικανότητά μας να αντιμετωπίσουμε" μια απειλή, εξήγησε στους δημοσιογράφους ο υπουργός Υγείας A. Azar.
www.bankingnews.gr
Η νέα αυτή στρατηγική παρουσιάστηκε με την ευκαιρία της συμπλήρωσης 17 ετών από τις επιθέσεις με άνθρακα που στοίχισαν τη ζωή σε πέντε ανθρώπους στις ΗΠΑ το 2001, τις εβδομάδες που ακολούθησαν τις επιθέσεις της 11ης Σεπτεμβρίου.
Προβλέπει τη συγκρότηση μιας διυπουργικής επιτροπής βιοάμυνας υπό τον υπουργό Υγείας A. Azar, με στόχο να συντονιστούν καλύτερα οι διάφορες υπηρεσίες που μπορεί να εμπλακούν (υπουργεία Άμυνας, Εξωτερικών, Εσωτερικής Ασφάλειας, Γεωργίας κ.α.).
"Για πρώτη φορά, μια κυβέρνηση στις ΗΠΑ εφαρμόζει μια εθνική στρατηγική βιοάμυνας που καλύπτει όλο το φάσμα των βιολογικών απειλών, είτε είναι φυσικές, είτε είναι σκόπιμες, είτε πρόκειται για ατυχήματα" ανέφερε σε ανακοίνωσή του ο Αμερικανός πρόεδρος D. Trump.
Διευκρίνισε επίσης ότι κάθε χρόνο η επιτροπή θα θέτει τις προτεραιότητές της "για να προλαμβάνει, να προετοιμάζεται καλύτερα, να ανταποκρίνεται και να διαχειρίζεται τις συνέπειες" στην περίπτωση τέτοιων συμβάντων.
"Είναι πραγματικά η πρώτη συνολική στρατηγική για να δούμε τι μπορούμε να κάνουμε, πού υπάρχουν κενά, ποιες είναι ανάγκες μας και η ικανότητά μας να αντιμετωπίσουμε" μια απειλή, εξήγησε στους δημοσιογράφους ο υπουργός Υγείας A. Azar.
www.bankingnews.gr














Σχόλια αναγνωστών